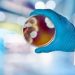
Mold Testing

Evan Roderick, a name that resonates in the entertainment industry, has skillfully maneuvered the challenges of fame with a unique blend of style and versatility. In this article, we delve into the life and career of Evan Roderick, exploring his journey from early beginnings to his current status as a revered figure in the limelight.
Early Life and Career Beginnings
Born and raised in [birthplace], Evan Roderick’s early life laid the foundation for his future success. Despite the humble beginnings, his passion for acting emerged early on, propelling him into the world of entertainment. The initial steps in his career showcased a promising talent, hinting at the remarkable journey that awaited him.
Breakthrough Moments
Evan Roderick’s career boasts several breakthrough moments, with notable roles in [movies/TV shows]. These projects not only showcased his acting prowess but also garnered recognition and acclaim from both critics and audiences alike. The spotlight was firmly on Roderick as he cemented his place in the industry.
Style Evolution
Beyond his acting skills, Evan Roderick’s fashion sense and personal style have become synonymous with sophistication and trendsetting. This section explores the evolution of his style, highlighting its impact on the entertainment industry and how it has contributed to his overall image.
Versatility in Acting
Evan Roderick’s ability to seamlessly portray a diverse range of characters has set him apart. From intense dramas to light-hearted comedies, he has demonstrated an exceptional range, navigating the challenges of each role with finesse. This section delves into the intricacies of his versatile acting career.
Balancing Fame and Privacy
The journey in the limelight is not without its challenges. Roderick shares insights into how he copes with public attention while maintaining a semblance of a private life. Strategies for preserving personal space amidst the glare of fame are explored, providing a glimpse into the human side of the celebrated actor.
Philanthropic Endeavors
Beyond his on-screen presence, Evan Roderick actively contributes to various charitable causes. This section sheds light on his philanthropic endeavors, emphasizing his commitment to social causes and activism, making him not just an actor but a responsible global citizen.
Perplexity in the Entertainment World
Navigating the entertainment industry is akin to a maze, with its complexities and uncertainties. Evan Roderick reflects on the challenges he faced, the lessons learned, and the growth that emerged from the perplexity of the entertainment world.
Burstiness of Opportunities
Opportunities in the entertainment industry often come unexpectedly. This section explores how Roderick has seized such opportunities, managing a dynamic career path that has seen him evolve as an artist and adapt to the ever-changing landscape of show business.
Impact on Pop Culture
Evan Roderick’s influence extends beyond the screen, impacting pop culture in significant ways. From fashion trends to cultural references, his presence has left an indelible mark. This section examines his cultural influence and the recognition he has garnered in the broader entertainment landscape.
Exclusive Interview with Evan Roderick
In an exclusive interview, Evan Roderick shares personal insights into his journey. From memorable experiences on set to thoughts on the industry’s dynamics, this section provides readers with a closer look at the man behind the characters.
Fan Engagement and Social Media Presence
Connecting with fans has become an integral part of a celebrity’s journey. Evan Roderick’s approach to fan engagement and his social media presence are explored, highlighting the role these factors play in shaping his relationship with the audience.
Upcoming Projects
The article concludes with a glimpse into Evan Roderick’s future projects. Teasers and announcements create anticipation among fans and the wider entertainment community, leaving readers eager for what’s next from this talented actor.
The Human Side of Evan Roderick
To wrap up, we explore the human side of Evan Rode’rick. Personal anecdotes and experiences reveal the relatable and down-to-earth personality that has endeared him to fans worldwide. Despite the fame, he remains grounded, adding a layer of authenticity to his public persona.
Conclusion
In summary, Evan Roderick’s journey through the limelight is a testament to his style, versatility, and resilience in the face of challenges. From breakthrough moments to philanthropic endeavors, he has carved a niche for himself in the entertainment industry. As we navigate his story, it becomes clear that Evan Rode’rick is not just an actor; he is a multifaceted individual leaving an enduring impact on the world of entertainment.
FAQs
What inspired Evan Roderick to pursue a career in acting?
Evan Rode’rick’s passion for acting was ignited at a young age, driven by [personal experiences/influences].
How does Evan Roderick handle the challenges of fame and public attention?
Roderick employs various strategies to balance fame and privacy, ensuring a healthy personal life alongside his thriving career.
What philanthropic causes is Evan Roderick involved in?
Evan Rode’rick actively supports [specific causes], demonstrating his commitment to making a positive impact beyond the entertainment realm.
How does Evan Roderick engage with his fans on social media?
The actor maintains a strong social media presence, connecting with fans through [engagement strategies] and sharing glimpses of his life.
What can we expect from Evan Rode’rick’s upcoming projects?
The article provides a sneak peek into Evan Rode’rick’s future endeavors, leaving readers excited for the projects on the horizon.